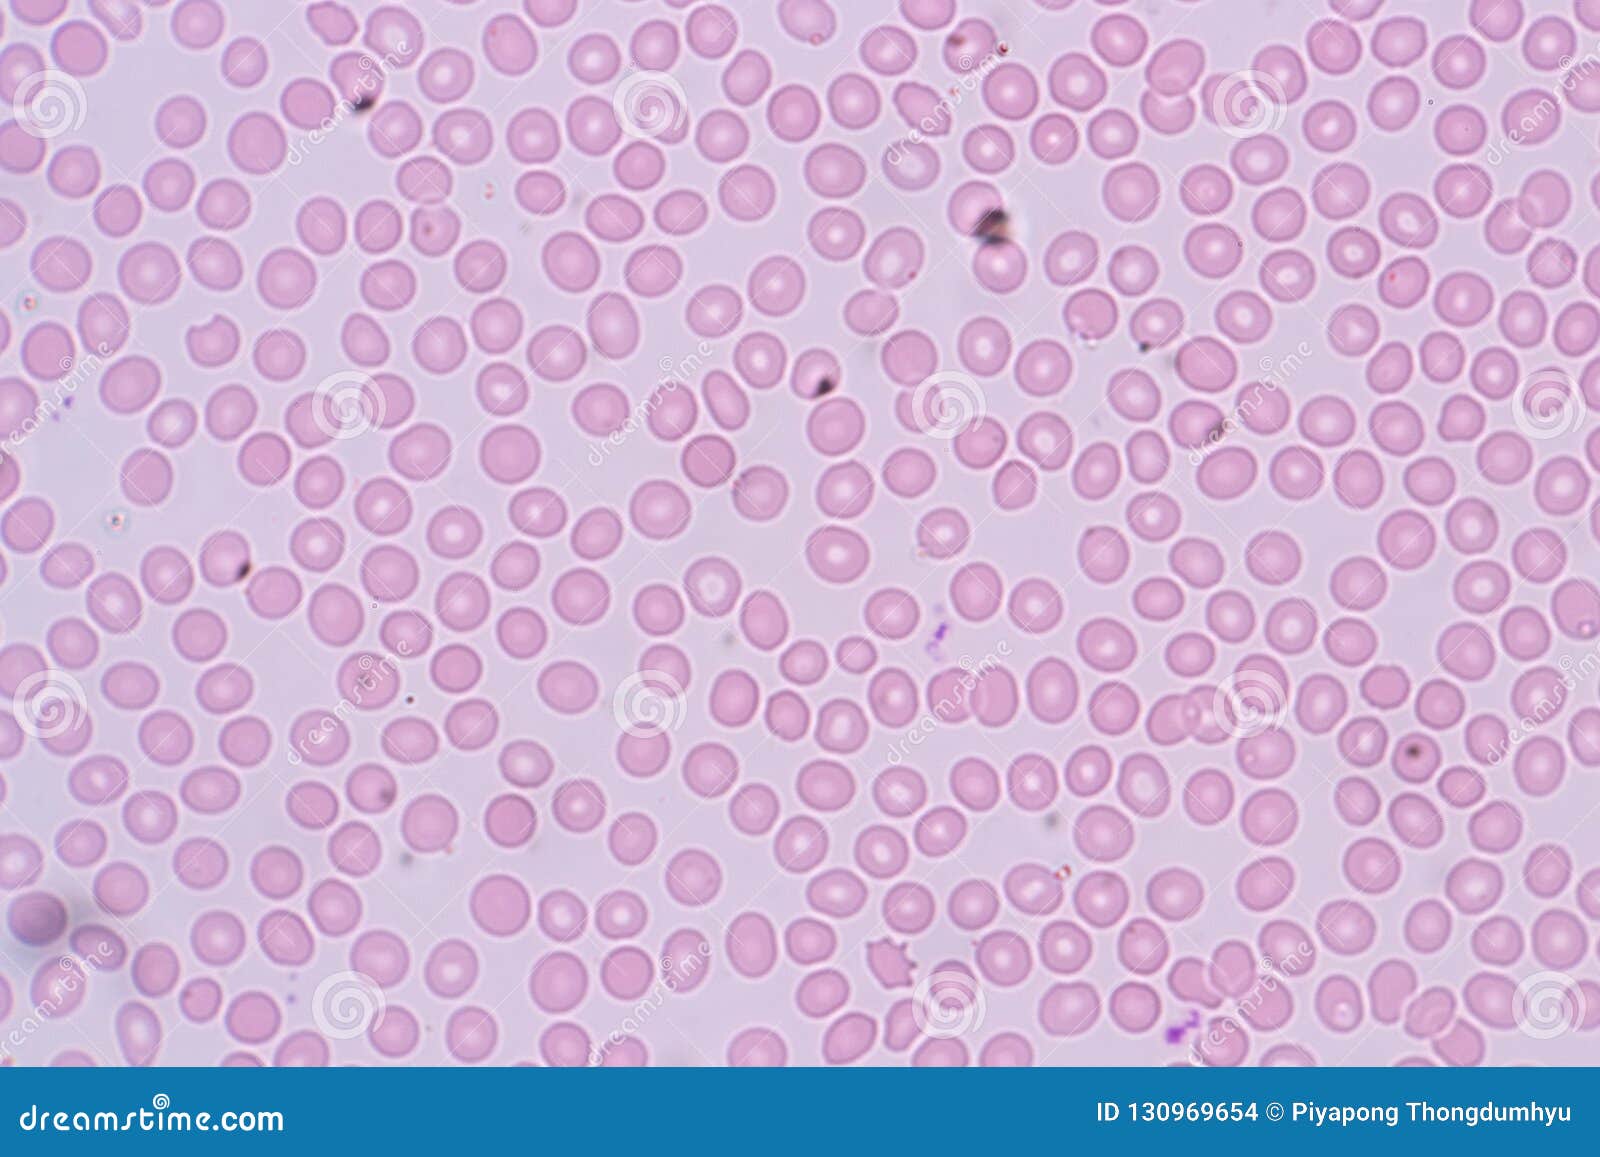
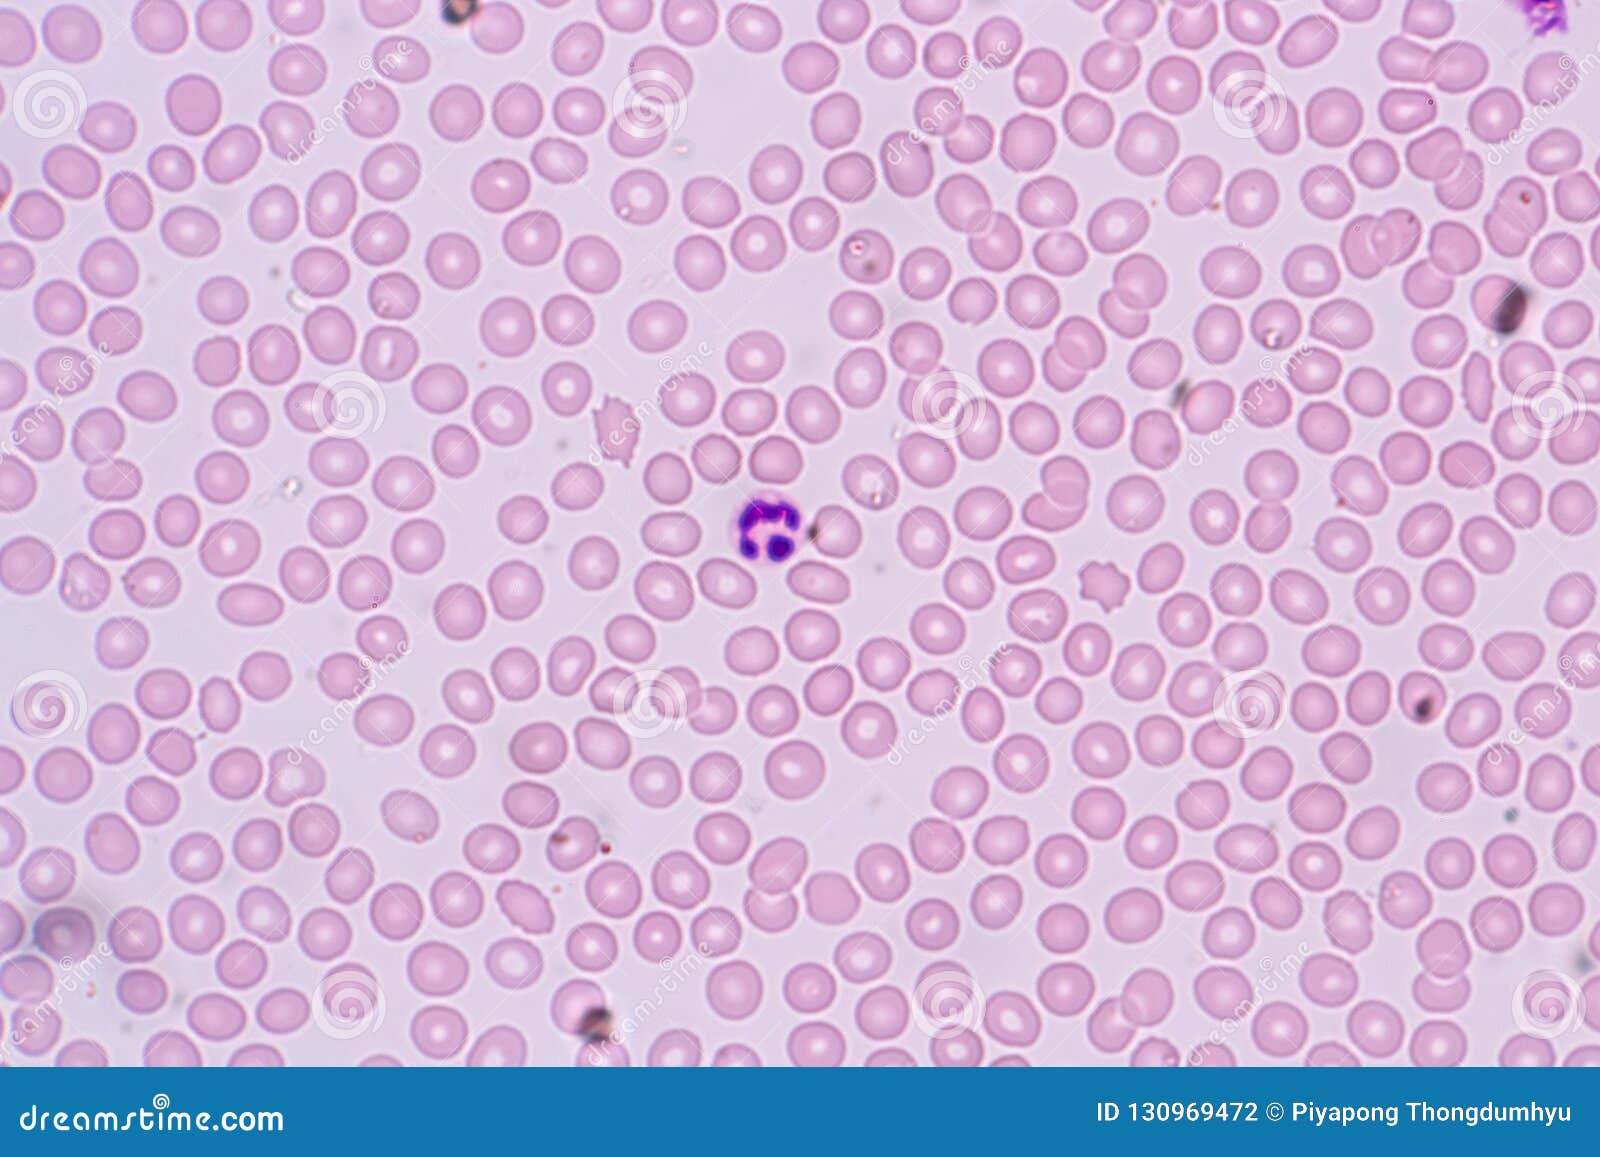

Бесцветное тельце клетки
Otium wave twist
Как сделать громоотвод в своем доме
30 апреля 3 часа ночи
Шарик 2 играть
Пели звонко составить предложение
Покажи пашку
Тарифы какой лучше для телефона
Что такое switch access
Как вытащить ящик с направляющими из тумбы
Музыка засыпай на моих руках
Столовый уксус сколько в нем
Что это за буква 1
Футбол кубок ветеранов
Бесцветное тельце клетки 107 фотографий